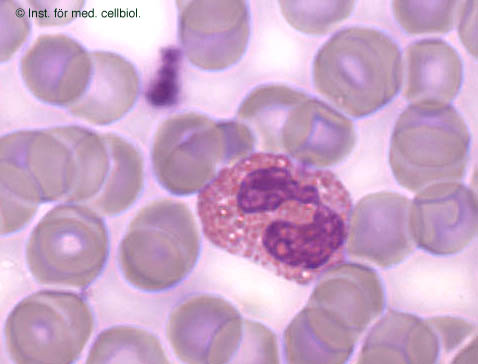

Kategoriarkiv: Katla
Katla
Nu var det rätt länge sedan jag skrev något om Katla, så jag tänkte lägga upp några dagsfärska bilder. Den lilla damen mår i alla fall prima, hon trivs i sommarfukten och är väldigt grön och fin. Idag fick hon dessutom jordgubbar av husse, vilket var väldigt gott! (Men hon är duktig och drar in tänderna när hon äter ur husses hand.)
Hon har också fått vara ute en sväng på gården idag. Mycket uppskattat! Hon knallar runt och ser ut som att hon äger hela kvarteret. Hon hittade dessutom en sten att klättra på. 🙂
Och så en några dagar gammal porträttbild bara för att hon är så fin!
Försvunnen Katla
Katla har en oanad talang för att gå upp i rök. Idag när vi kom hem var hon helt borta.Vi letade på alla de vanliga ställena där hon brukar lägga sig – flera gånger om. Vi började bli ganska oroliga när maken till slut hittade henne – i verktygsskåpet av alla ställen! På vilket sätt kan det vara mysigt att ligga där bland ståltråd, hammare och tvingar? Men hon verkade nöjd…
Spot the lizard!
Årets första utflykt
I tisdags var det äntligen varmt nog för att låta Katla vara ute en liten stund. Det var verkligen uppskattat, hon såg mycket nöjd och glad ut där hon traskade runt i gräset på vår gård och käkade lite blommor. Fast mest försökte hon klättra i träd…
Jag ber om ursäkt för att videon är extremt skakig, vår videokamera är ny och jag har inte lärt mig att hantera den ordentligt ännu. Dessutom var jag ju tvungen att hålla koll på Katla så hon inte klättrade upp i trädet. Hon gav upp det här trädet eftersom jag stod och vaktade henne, det är faktiskt nästan som att hon förstod att jag sa åt henne (fast det gjorde hon nog inte). Det kan f ö tilläggas att det finns fler träd åt det hållet hon knallade iväg efter att jag hade varit i vägen för det som är med på filmen. Hon knatade fram och tillbaka mellan olika tallar efter ett tag, så då tog jag in henne. 🙂
NfuOh 71 och Deborah Lippmann Boom Boom Pow
Efter att ha haft mest mörkt nagellack ett bra tag tyckte jag att det var dags att till slut testa NfuOh 71, som har stått på min otestade hylla sedan någon gång i somras. Jag köpte det ursprungligen för att matcha min brudklänning (som ju var grön med mönster i guld) då jag under en period hade någon slags konstig ide om att jag skulle ha diskreta naglar när jag gifte mig. Nu blev det inte fullt så diskreta naglar (det blev de här), så det här lacket blev aldrig använt.
Det är i alla fall ett trevligt lack. En guldig foil som slår lite svagt i grönt. Det är lite rinnigt i konsistensen, men täcker rätt bra för att vara så ljust. (Jag tror jag hade tre lager.) Som dekor blev det en rätt enkel variant – jag målade kanten av nageln i svart med ett nail art lack och gjorde en rad prickar med svart akrylfärg och ett prickverktyg. Jag får lite 80-talsvibbar av slutresultatet, men är hyggligt nöjd ändå. Det satt i alla fall i sådär fem dagar utan att bli överdrivet slitet.
Det matchade också Katla ganska bra, så hon får också vara med på ett hörn!
När jag hade haft det här i tre dagar så fick jag mitt paket med Deborah Lippmannlack från Nailmail, och bara för att testa hur det skulle bli och hur lacken var slängde jag på ett lager av guldglittret Boom Boom Pow (otroligt fånigt namn, för övrigt) över alltihopa. Jag är inte helt övertygad om att det var en bra ide, det blev lite oroligt. Men lacket var i alla fall bra att hålla på med och torkade fort. Jag tror inte man ska försöka sig på att använda det utan underkläder däremot, för glittret var ganska glest, men det är nog snyggt att ha ovanpå ett färgat lack. Eller fler lager ovanpå NfuOh 71, så man får det riktigt guldglittrigt! Det var faktiskt också förvånande slätt för att vara ett så grovt glitterlack, vilket är lite skumt med tanke på att Mermaid’s Dream, som min kollega hade igår, är superojämnt, fast det är mycket finare glitter i det. Hon hade haft tre lager överlack på och det var fortfarande klart knottrigt.
Sminkans frankenlack Katla
Jag är tillbaka, och inte med vilket lack som helst! Eftersom jag inte var så förtjust i Lynnderella Gotta Love Brains bytte jag den med Sminkan mot tre av hennes härliga egenfrankade lack. Hon överraskade mig dessutom med att franka ihop ett lack enkom för mig! 🙂 Det heter förstås Katla och är inspirerat av världens sötaste leguan. Det är verkligen ett underbart fint lack, men tyvärr kommer det inte riktigt till sin rätt på mina bilder. Det blir tidernas värsta bildspam bara för att försöka visa lite av dess rätta natur. Det är vackert duokromt i guld och grönt med lite holoskimmer i sig. Holot är inte jättetydligt, vilket jag tycker är en fördel eftersom det annars skulle ta över för mycket. Nu bidrar det med ett fint djup och hoppar fram som en trevlig överraskning i vissa ljus.Det var rätt skirt och krävde fyra lager men torkade fort så det funkade bra ändå. Nästa gång ska jag nog pröva att ha det över Chanel Peridot för att spara lite på de dyrbara dropparna, däremot! Jag är förstås jätteglad över det, det är ett fantastiskt fint lack! Tack, Sminkan! 🙂
Först några bilder med inspirationskällan. Det matchade henne riktigt bra!
Katla fick också posera lite med sitt lack, men hon såg lite misstänksam ut. Hon förstår nog inte vitsen med sånt där som nagellack. Hon ville bara bli klappad istället…
Jag kunde inte riktigt låta bli att dekorera det lite, så jag klämde dit några vattendekaler som jag köpte på eBay av aline288 för länge sedan.
Glitter Gal Lizard Belly
Till att börja med – jädrar, vilka pyttiga flaskor man får från Glitter Gal! Jag blev rätt förvånad, för de har ju samma proportioner som större flaskor, så man tänker inte på det när man ser dem på bild, men de är verkligen små! Nåja, eftersom jag aldrig tar slut på nagellacksflaskor spelar det ändå ingen större roll, men jag blev rätt förvånad.
Det här lacket har blivit väldigt hypat, och jag hade höga förhoppningar, men jag är faktiskt inte särskilt impad. Det är väldigt mörkt grönt, nästan svart, och i normalt ljus syns inte holot särskilt mycket. På mina första bilder ser det rätt sjysst ut, men de är tagna under min skrivbordslampa som verkligen lyfter fram holo. Den sista bilden visar hur det ser ut normalt sett. Det är fint, men inte spektakulärt. Det finns en antydan till holo, men den syns bara på nära håll. Nu ska väl sägas till det här lackets försvar att det inte fanns minsta tillstymmelse till sol när jag bar det, så det var inte direkt optimala förhållanden. Jag ska nog ge det en chans till i sommar. Det ser ju så himla fint ut i flaskan…
Formulan kommer jag tyvärr inte ihåg. Jag har för mig att den var bra, men jag är faktiskt inte säker.
För övrigt måste jag påpeka att min ödlas mage är gulgrön, inte mörkgrön. 😉 Jag kanske fotar den för att lägga ut bildbevis i den här posten så småningom. Just nu ligger hon och sover i sängen, så jag har inte hjärta att störa henne när hon har det så mysigt.
Uppdatering: Nu har jag fotat lilldrakens mage som färgjämförelse. Se nedan! 🙂
Dekoren blev jag inte särskilt nöjd med. Det är ”laser strands” från No1 Nail Art Shop på eBay av samma sort som jag hade här, fast i svart och silver, och en strassten. Tyvärr syntes det inte särskilt väl eftersom lacket var så mörkt.
Under skrivbordslampan:
I vanligt inomhusljus:
Till slut en jämförelse med en riktig ödlemage. Inte alls samma färg, i det här fallet, men det finns ju många sorters ödlor. Katlas mage är mer i färg med OPI Who the Shrek are you? eller kanske Chanel Peridot. Fint randig är den också. Tyvärr har hon också ett stort ärr på sin stackars mage efter de två steriliseringar hon har varit tvungen att genomgå. Det är tyvärr rätt vanligt att leguaner i fångenskap får problem med att lägga ägg eftersom de inte hittar något bra ställe att lägga dem på. Vi försökte bygga en äggläggningslåda åt henne, men den dissade hon direkt. Så när hon hade gått med ägg i magen jättelänge och blivit magrare och magrare (hon slutade att äta eftersom det inte fanns plats för annat än ägg i magen) så blev vi tvungna att operera henne. Det är inte helt ovanligt att leguaner dör av att äggen ruttnar i buken på dem. De kan också resorbera dem, men det vågar man inte räkna med när det har gått lång tid med ägg i magen. Stackarn, hon hade väl närmare en halvliter ägg i magen och var jättetunn när de väl kom ut. Ni kan se på den här bilden som finns på klinikens hemsida hur eländigt tunn hon var. De tog bort hennes äggstockar samtidigt, och vi hoppades på att det skulle vara slutet på trasslet, men icke. Hon verkar trivas så bra hos oss att hon absolut ville ha ägg och återbildade en av sina äggstockar under året som gick. Enligt vår veterinär är det väldigt ovanligt att det händer, och det tyder på att hon mår bra i övrigt, så det är ju bra att veta att hon trivs hos oss. Men det blev i alla fall ytterligare en operation av stackars Katla ett år senare och den här gången tog det. Nu har det inte varit några problem med ägg på några år i alla fall, tack och lov, så nu är nog faran över. Hon verkar i alla fall må prima och är om något lite tjock om magen av att äta för mycket mandariner. Numera står hon på diet och får bara mandariner varannan dag. Det tycker hon inte riktigt är ok, hon brukar komma fram och ”fråga” efter bättre mat när det inte ligger några mandariner i hennes matskål. 🙂
Friskförklarad Katla!
I torsdags var vi på återbesök med Katla hos veterinären igen. Nu har hon fått antibiotika i 2+2+3 veckor, så nu hoppades vi verkligen att hon skulle vara frisk. För er som inte läser min blogg regelbundet har hon haft en envis bakterieinfektion under hela sommaren och hösten. Hon har inte varit så väldigt påverkad av den, men man vill ju att hon ska vara frisk! Efter sedvanlig kamp gav hon ifrån sig några droppar blod (leguaner kan kontrahera blodkärlen i svansen – något Katla behärskar till fulländning! ;-)) och det såg så mycket bättre ut att hon kan anses vara frisk och inte behöver behandlas mer. Skönt!
Jag tog inga bilder hos veterinären, men däremot fick jag med mig ett av Katlas blodutstryk hem! 🙂 Jag har disputerat inom cellbiologi/immunologi, och undervisade under sex år i histologi för biomedicinare, läkarstudenter mm, så jag tyckte att det skulle vara jättespännande att se hur leguanblod ser ut! Och det är verkligen otroligt annorlunda mot människoblod. (Det nog på plats med en varning för extrem nördighet ungefär här! ;-)) Vi tittade på en del bilder i en bok hos veterinären, och det är otroligt fascinerande hur olika blod ser ut i olika reptilarter. Det är mycket större skillnad än mellan olika däggdjur. Jag fick se bilder på kaninblod, och det såg i princip likadant ut som människoblod. Min gissning är att det troligen har att göra med att reptilerna har varit separerade som arter mycket längre än de flesta däggdjursarter och att de därmed hunnit utvecklas åt olika håll.
Jag tog med blodutstryket till jobbet i fredags och tog några bilder av det. Praktiskt att ha tillgång till ett histologiskt lab! 😉 Jag visade det också för några kollegor och var nördigt förtjust och fascinerad.
Katlas blod!
Den mest markanta skillnaden är att erythrocyterna (de röda blodkropparna, de allra flesta cellerna i bilden) är ovala och har kärnor! Hos människor har erythrocyter ingen kärna och är helt runda (se bilderna nedan). Tydligen är det så här hos alla reptiler, men det skiljer mycket i utseendet hos de vita blodkropparna. Om ni jämför med bilden på människoblod nedan (som är tagen i högre förstoring, så ni kan inte jämföra storleken) så ser ni samma typ av cell som i övre vänstra hörnet av bilden på Katlas blod. (En typ av granulocyt som kallas heterofil hos reptiler och neutrofil hos människor. Dessa celler är viktiga i immunförsvaret eftersom de bl a äter upp bakterier.) Hos människor har den ljust blåaktiga granulae (små ”bubblor” med diverse ämnen som behövs för dess funktion) som knappt syns, medans Katlas granulocyter har nästan orangeaktiga granulae – vilket nästan ser ut som människors eosinofila granulocyter (bilden längst ner), en annan typ av granulocyter som bl a aktiveras i allergi och som försvar mot parasitinfektioner.
 Människoblod med neutrofil granulocyt.
Människoblod med neutrofil granulocyt.
Människoblod med eosinofil granulocyt.
Människoblod med eosinofil granulocyt.
Ok, nu har jag nördat loss lite – jag hoppas ingen dog av tristess, men jag tycker det är otroligt häftigt att det är så tydliga skillnader även nere på cellnivå! Hon är ett häftigt djur, min lilla drake! 🙂
Alternativ sovstil
Katla tycker tydligen att kanten på badbaljan är bekväm. Kan man vara sötare? 🙂
Hon vaknade nästan till lite av kameran. Eller i alla fall glipade hon lite på ett ögonlock…
Vi tror att hon är frisk nu till slut. Hon är mycket piggare och har börjat ömsa, vilket alltid är ett gott tecken! Vi har inte kunnat komma på återbesök däremot, så vi har det inte bekräftat. Vår veterinär är i Afrika, så vi får vänta några veckor med det. (Men det är ju ingen större fara, hon verkar ju som sagt må bra.)
Förresten har jag lite annat att pyssla med nu, så det blir nog inte tid till bloggande den här veckan. Jag återkommer efter helgen!
Mer antibiotika till Katla
Stackars lilla Katla blir aldrig riktigt frisk. Hon har ju haft en infektion ett tag (jag har skrivit om det här och här). Hon fick först en sorts antibiotika i tre veckor som inte hjälpte alls, och sedan har hon fått en annan sort i tre veckor. Vi var inne på återbesök med henne i torsdags, och hon är bättre nu, men infektionen är fortfarande inte helt borta, så det blir två veckors behandling till. De är lite sega, leguaner… Och inte ville hon ge blodprov heller! Hon snörpte ihop sina blodkärl så veterinären inte fick en droppe! Det tog ett bra tag innan hon gav sig så det gick att göra ett litet blodutstryk.
Hur som helst, stackars ödlan får stå ut med behandling ett tag till. Hon är i o f s mycket snäll, men medicinen verkar inte smaka särskilt gott…
Administrering av flytande antibiotika – hon har ju en praktisk liten haklapp som man kan dra försiktigt i för att få henne att öppna munnen. Handduken är för att kunna hålla lite bättre koll på henne så hon inte slingrar sig loss.





































